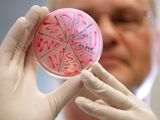
Язвы на коже и слизистых оболочках

Первый шаг к успеху — правильный выбор ингредиентов. Для идеального творожного пирога в домашних условиях вам понадобится качественный творог, лучше всего использовать домашний или высококачественный магазинный. Также важно правильно выбрать муку — используйте пшеничную муку высшего сорта, чтобы избежать лишней крошливости коржа.
Теперь давайте поговорим о технике приготовления. Чтобы добиться идеальной консистенции теста, важно правильно смешать ингредиенты. Начните с смешивания муки и разрыхлителя в отдельной миске, затем добавьте яйца и сахар. Взбейте смесь до однородной консистенции, затем постепенно добавляйте творог, продолжая взбивать до получения гладкого теста.
Для приготовления пирога в духовке, сначала необходимо подготовить форму для выпечки. Используйте форму с разъемным дном, чтобы легко извлечь пирог после выпечки. Смажьте форму маслом и присыпьте мукой, чтобы пирог не прилипал. Вылейте тесто в форму и выпекайте в предварительно разогретой духовке при температуре 180 градусов в течение 30-35 минут, или до тех пор, пока зубочистка, вставленная в центр пирога, не выйдет чистой.
Подготовка ингредиентов и формы
Прежде чем приступить к приготовлению, убедитесь, что все ингредиенты готовы. Для этого заранее достаньте из холодильника сливочный сыр, чтобы он нагрелся до комнатной температуры. Это облегчит процесс смешивания и сделает текстуру более гладкой.
Также, не забудьте заранее разогреть духовку до нужной температуры. Это поможет равномерному приготовлению и предотвратит образование трещин на поверхности.
Для выпечки используйте разъемную форму для выпечки, чтобы легко извлечь готовый десерт. Застелите дно формы пергаментной бумагой, чтобы предотвратить прилипание и облегчить извлечение.
Если у вас нет разъемной формы, можно использовать обычную форму, но тогда нужно будет смазать ее маслом и присыпать мукой, чтобы десерт не прилипал.
Также, не забудьте подготовить все необходимые инструменты, такие как миксер, венчик, мерные чашки и лопатка для теста. Это поможет вам работать быстрее и эффективнее.
Приготовление теста и начинки
Начните с приготовления теста для основы чизкейка. Вам понадобятся 200 грамм песочного печенья, 100 грамм сливочного масла и 1 ст.л. сахара. Измельчите печенье в крошку, смешайте с растопленным маслом и сахаром. Полученную смесь выложите в форму для выпечки и равномерно распределите по дну. Запекайте основу в предварительно разогретой до 180 градусов духовке в течение 10 минут.
Пока основа печется, приготовьте начинку. Для этого вам понадобятся 500 грамм творожного сыра, 150 грамм сахара, 3 яйца, 200 грамм сметаны и ванилин. Взбейте творожный сыр с сахаром до однородной массы. Добавьте яйца по одному, взбивая после каждого. Добавьте сметану и ванилин, снова взбейте до однородной массы.
Когда основа готова, выньте ее из духовки и дайте остыть. Затем выложите начинку на основу и разровняйте поверхность. Запекайте чизкейк в духовке при температуре 160 градусов в течение 45-50 минут. Готовый чизкейк остудите при комнатной температуре, затем поставьте в холодильник на несколько часов перед подачей.